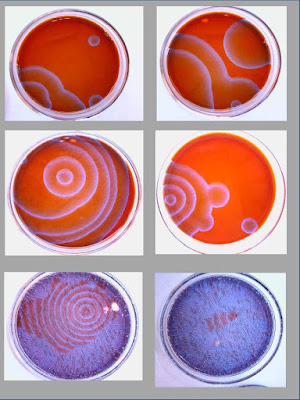

Procesos naturales, modelos y
sistemas
Los humanos parecemos tener una
compulsión, innata o que se estabiliza en los primeros años de
vida, tendente a percibir todo (y a describir todo lo que percibimos)
en forma secuencial (temporal), espacial, y causal (en cadenas de
causa-efecto) (véase v.g. La síntesis Kantiana entre racionalismo y empirismo; Schopenhauer: el mundo como Voluntad y representación; Las metáforas y la construcción imaginaria de la realidad).
Somos sistemas complejos sometidos a un proceso permanente de cambio,
y que construye representaciones sobre lo que es el mundo, a partir
de percepciones muy puntuales procedentes de éste. Esto no significa
que cualquier representación que podamos crear tenga la misma
validez práctica. Dentro de nuestras limitaciones constitutivas, no
todas las descripciones espacio-temporales y causales que podemos
hacer de la realidad se ajustan a lo que observamos de forma
consistente y coherente, es decir, de forma pragmáticamente útil a
la hora de manipular y de predecir el comportamiento futuro de los
objetos observados. El llamado “conocimiento científico” no es
sino el estado actual de esa pragmática en la que un conjunto de
metáforas y conceptos sobre supuestos objetos reales (y clases de
objetos) ha sido aceptado como el conjunto cuya coherencia y
consistencia intrínseca (de unos conceptos observacionales con los
otros) es máxima.
Las descripciones
científicas de la realidad se hacen utilizando modelos, que son
conjuntos muy especiales de metáforas y conceptos. Un modelo
contiene un conjunto de teorías generales sobre la clase de objetos
a la que supuestamente pertenece el objeto descrito y también un
conjunto de hipótesis auxiliares sobre características únicas del
objeto que estamos describiendo y el ambiente que le rodea.
Normalmente, los modelos científicos se construyen en forma
matemática.
En las “instrucciones de uso” de un
modelo también hay que definir la "escala espacio-temporal"
en la que se debería observar la realidad para poderla comparar con
lo que el modelo predice (o escala espacio-temporal de aplicabilidad
del modelo) y la definición de lo que debería considerarse como
“las variables de interés” del objeto observado. No todas las
propiedades observables en el objeto las consideramos importantes y
relevantes para el modelo; sólo algunas de ellas. El conjunto
elegido constituye el "sistema de interés". Esta elección
de variables y escala del “observador-modelador” tendrá pues un
importante efecto sobre los resultados y predicciones que se
obtendrán del modelo.
Hay algunos casos en los que la
relación particular entre ''observador-modelador'' y ''objeto
observado-modelado'' puede ser olvidada sin que los resultados del
modelo pierdan validez. Son aquellas en las que existe un acuerdo
previo e incontrovertido entre las diversas partes interesadas que
utilizarán el modelo, sobre cómo interaccionarán con el objeto,
sobre la ‘‘escala espacio-temporal’’ a la que interesa
observarlo (por ejemplo, los distintos ambientes, momentos y
geografías en los que los actores observarán al objeto real no lo
afectarán hasta el punto de convertirlo en otra cosa a una velocidad
que requeriría un análisis evolutivo complementario) y hay también
un consenso previo sobre lo que debería considerarse como "el
sistema de interés", dentro de la variedad de detalles
diferentes con los que se puede presentar una misma clase de objetos
en momentos y sitios diferentes y para observadores diferentes.
En los apartados que siguen resumiremos
la forma como la ciencia actual ha llegado a concebir los procesos de
cambio en los objetos más complejos que percibe y describe, y
analizaremos dos ejemplos concretos: la biosfera y el sistema
climático.
Sistemas disipativos y sistemas
auto-organizativos
Todos los sistemas naturales de interés
para la sostenibilidad y para la supervivencia de los humanos sobre
el planeta Tierra (por ejemplo, los ciclos biogeoquímicos complejos,
las células vivas que realizan la fotosíntesis, los sistemas
ecológicos, o los sistemas humanos cuando se analizan en diferentes
niveles de organización y escalas por encima de la molecular) son
“sistemas disipativos”. Esto es, son sistemas atravesados por
flujos de energía, lejos del equilibrio termodinámico, y afectados
por procesos auto-organizativos.
Ejemplos de procesos auto-organizativos
relativamente simples son los cilindros de agua rotante (o las
columnas hexagonales) que se forman en una caja con agua calentada
por debajo; o las ondas y espirales que se producen en las
reacciones químicas no-lineales, como la de Belusov-Zhabotinski, y
que a veces siguen una pauta periódica y otras se generan de forma
caótica e impredecible.
Resumamos las características de los
procesos auto-organizativos. (i) Se dan en sistemas alejados del
equilibrio y abiertos a la energía y/o a los materiales externos,
por lo que no son sistemas hamiltonianos (que conservan su energía
total) sino sistemas abiertos disipativos (que toman energía de baja
entropía del medio, la hacen circular entre sus componentes, y la
dejan salir de nuevo al medio con mayor entropía de la que entró).
(ii) Muestran creación espontánea (no
buscada por el observador humano) de inhomogeneidad y cambios
cualitativos donde su estado previo era homogéneo y/o estable.
(iii) Sus variables observables a
escala macroscópica (como la temperatura o la densidad) interactúan
de un modo no-lineal. En los modelos matemáticos de los sistemas de
este tipo, cuando hay más de dos variables (y una variable que varía
espacialmente, como las de un fluido, equivale a infinitas variables)
el sistema puede generar atractores para la evolución de sus
variables, esto es, trayectorias recurrentes hacia las que las
variables del sistema tienden. Los atractores pueden ser
estacionarios, ciclos limite, ciclos multiples, o atractores
caóticos.
Desde el punto de vista del modelo
matemático, la estructura disipativa se produce cuando el sistema,
que estaba inicialmente en un estado estacionario (típico en muchos
sistemas termodinámicos abiertos), (a) pierde la estabilidad y (b)
cae en otro atractor de igual o mayor complejidad.
¿Cómo se produce la inestabilización
del sistema? Prigogine distingue tres formas: (a) por la aparición
de una fluctuación suficientemente intensa de las componentes, que
desestabiliza el atractor actual de la dinámica macroscópica del
sistema; (b) por cambio en los parámetros externos que controlan los
flujos, fuerzas termodinámicas, interacciones entre las partículas
o probabilidades de interacción entre los subsistemas
("inestabilidades sinergéticas" sistematizadas
posteriormente por H. Haken), o (c) por inestabilidad estructural
ante la aparición de nuevos componentes y/o nuevas interacciones
("inestabilidad estructural ante la aparición de nuevas
variables").
La primera clase de inestabilidad es
muy improbable en sistemas con atractores intensos que llevan
funcionando establemente mucho tiempo, porque esto mismo es una
demostración de que son estables ante las fluctuaciones estadísticas
habituales en sus componentes y en el entorno; pero todo sistema
compuesto de partes es sólo “metaestable”, esperando el tiempo
suficiente es siempre posible que aparezca una fluctuación
estadística que meta en el sistema una concentración de energía
anómala del entorno, o que lleve una gran parte de la energía del
sistema hacia un grupo de componentes que, al moverse
sincronizadamente, pueden romper la (meta)estabilidad del sistema.
En las inestabilidades de tipo (b)
(sinergéticas), los parámetros del medio ambiente dentro del cual
está el sistema pueden ir modificándose lentamente a lo largo de
periodos de tiempo mucho más dilatados que los tiempos típicos de
cambio del propio sistema; ello puede acabar volviendo inestable a
los atractores que ordenan el comportamiento del sistema. Éste puede
volverse inestable porque se modifiquen las tasas de interacción con
el entorno, las restricciones externas, o las probabilidades de
interacción entre sus subsistemas componentes (por ejemplo,
partículas). Esto último genera una posibilidad adicional de
comportamiento complejo, pues tales probabilidades de interacción
pueden estar siendo modificadas por alguna de las emergencias
macroscópicas generadas por la interacción de los componentes.
La aparición de columnas de convección
de forma hexagonal en sistemas naturales o de laboratorio se pueden
predecir mediante esta clase de modelos sinergéticos.
![]() |
| Columnas de convección formadas espontáneamente en un lago salino |
La reacción de Belousov-Zhabotinsky es
otro ejemplo. El atractor estacionario del sistema se ha debilitado
por variación de sus parámetros, y pequeñas perturbaciones locales
producidas por la propia turbulencia del fluido, por una vibración
sonora, o por la acumulación casual de muchas moléculas de ácido
malónico en un mismo punto, pueden desencadenar la amplificación
de una pauta macroscópica, que en cada momento es diferente, como
muestra la figura siguiente.
Las inestabilidades del tercer tipo son
importantes cuando estructuras previamente autoorganizadas y que
tienen cierta (meta)estabilidad se encuentran unas con otras y alguna
propiedad emergente de una afecta a la dinámica de la otra. La
aparición de simbiosis o endosimbiosis entre células simples puede
modelarse en principio mediante esta clase de inestabilización de
estructuras previas que se encuentran por azar.
![]() |
| Las células eucariotas parecen haber surgido de la entrada simbiótica de células procariotas dentro del citoplasma de otra célula procariota receptora |
Aún no se ha podido encontrar una ley
universal válida para la evolución de cualquier sistema alejado del
equilibrio. Lo más que se puede hacer es construir el diagrama de
bifurcaciones e inestabilidades para las clases de sistema cuya forma
de inestabilizarse tiene una estructura matemática recurrente. Al
hacerlo, conviene tener en cuenta que: (i) el sistema puede contener
impurezas e influencias no consideradas al escribir las ecuaciones,
que proceden de escalas inferiores (escala “micro”) a la de
observación (escala “macro”); (ii) no siempre se puede aislar el
sistema de la aparición de nuevos elementos y/o interacciones a
nivel microscópico (a escala de los constituyentes); (iii) hay que
considerar, además, las fluctuaciones de las variables macro
relevantes (originadas muchas veces en la impredecibilidad de
comportamiento de los componentes), su probabilidad, y su influencia
en la trayectoria del sistema por su “espacio de fases” (conjunto
de valores accesibles a sus variables macro v1,v2…vn).
Por ello, la predicción de los modelos suele dar la probabilidad
P(v; t) de que en el tiempo futuro t el
estado del sistema sea v= (v1,v2…vn).
Si no hubiera fluctuaciones, P sería siempre una distribución de
varianza nula o "delta de Dirac" (trayectoria
determinista); debido a la existencia de fluctuaciones y
perturbaciones impredecibles, y la forma como las interacciones
internas del sistema reaccionan ante ellas, las variables vi
se distribuyen con cierta probabilidad en torno a una trayectoria
media en muchos sistemas naturales. Las fluctuaciones y su forma
estadística se convierten en determinantes en momentos en que un
atractor se convierte en inestable o se bifurca. Por ello, en tales
momentos las descripciones macro y mesoscópica se vuelven
insuficientes, y se suele recurrir al uso de ecuaciones, llamadas
"master", para la evolución de la probabilidad P.
Finalmente, hay un tema de reflexión
muy interesante, y es el de cuál es el rasgo común que tiene el
proceso de inestabilización del estado estacionario en sistemas tan
distintos como una reacción química y un fluido por ejemplo, y por
qué tal estado nunca se vuelve inestable cuando el sistema está
“cerca del equilibrio” (atravesado por flujos débiles de
energía). ¿En qué consiste esa retroalimentación positiva o
catálisis entre componentes micro que desestabiliza el estado
estacionario y genera una pauta macro nueva? Una respuesta heurística
a esta cuestión podría ser la siguiente:
En los sistemas cerca del equilibrio,
las fluctuaciones no son lo suficientemente intensas como para
provocar encuentros lo suficientemente frecuentes entre los elementos
micro.
Por contra, si hay mayor densidad de
energía, materiales y momento atravesando al sistema, en forma de
fuertes flujos y fuerzas termodinámicas (que aumentan las energías
internas y/o potenciales), habrá mayor energía disponible para
fluctuaciones grandes (y pequeñas).
Por otro lado, los encuentros entre los
constituyentes (colisiones si son partículas) generan propiedades
emergentes que (i) son posibilitadas por los encuentros y (ii) muchas
veces se intensifican con la frecuencia de encuentros. Y tales
propiedades emergentes facilitan (probabilísticamente) la
continuación del tipo de encuentros que es capaz de producirlas (en
un verdadero "embuclamiento" micromacromicro).
En esto parece consistir en general la autocatálisis, que es el
rasgo principal de la auto-organización.
Muchas veces, la autocatálisis
producto de las colisiones (o los encuentros, o las interacciones
entre componentes) basta para generar emergencias como las
correlaciones a largas distancias de las propiedades macroscópicas
generadas por esas sincronizaciones micro.
Es importante resaltar que la
metodología reduccionista utilizada por la ciencia mecanicista hasta
bien entrado el siglo XX presupone que explicar el comportamiento o
las propiedades del todo a partir de sus partes es “objetivo”
mientras que explicar el comportamiento de las partes a partir del
todo, eso no es objetivo ni científico. Sin embargo, la retroacción
de la propiedad emergente macroscópica sobre el comportamiento (o
las propiedades) de los constituyentes es algo que aparece una y otra
vez en procesos complejos; y esta evidencia es devastadora para las
pretensiones del reduccionismo (Rosen, 1993). La aplicabilidad de
éste debe ser circunscrita en lo sucesivo a situaciones muy
particulares del objeto y de los sujetos que lo describen.
Sistemas que se auto-mantienen
Los sistemas que se automantienen son
sistemas constituidos por sistemas auto-organizativos cuyos
atractores (estacionarios o cíclicos) mantienen a sus variables
macro emergentes en cierta (meta)estabilidad. De este modo, los
sistemas auto-organizativos componentes pueden permitirse mantener
cierta persistencia en la interacción de sus propiedades (variables)
emergentes con las de otros componentes. Pero además, y este es el
rasgo esencial de los sistemas que se automantienen, los sistemas
componentes se producen unos a los otros de forma operacionalmente
cerrada (Hejl 1984). Esto es, los materiales y energía requeridos
por cada componente proceden de los materiales y energía liberados
por otros componentes. Para resaltar y modelar la materialidad de
esos flujos en red entre los ingredientes de un ensamblaje que se
automantiene, el concepto de red o hiperciclo de auto-mantenimiento
puede ser de gran utilidad. Se trata de un esquema de flujos
materiales (y energéticos) entre los componentes del sistema, tal
como el de la Figura siguiente.
Los sistemas que se auto-mantienen son
la consecuencia de un bucle de retroalimentación constructivo
(organización) que permite la regeneración continua de los
componentes (Varela 1974).
Los lazos causales y materiales
cerrados que son característicos de los sistemas que se
auto-mantienen impiden la posibilidad de explicar de forma
reduccionista (a partir de las propiedades de las partes únicamente)
el comportamiento de tales sistemas (Rosen 1993).
Sistemas auto-poiéticos
Los sistemas auto-poiéticos se pueden
considerar casos especialmente complejos de sistemas que se
auto-mantienen. Un sistema autopoietico se organiza (definido como
una unidad) como una red de procesos de producción (transformación
y destrucción) de componentes que producen los componentes que:
1. a través de sus interacciones y
transformaciones, continuamente regeneran y realizan la red de
procesos (relaciones) que los produjeron; y
2. Lo constituyen [al sistema que se
auto-mantiene] como una unidad concreta en el espacio en el que [los
componentes] existen especificando el dominio topológico de su
realización como tal red (Varela 1979).
Un sistema autopoiético es siempre un
sistema que se auto-mantiene. Pero la característica clave de un
sistema autopoiético es el mantenimiento de su organización, es
decir, la preservación de la red relacional que lo define como una
unidad sistémica. Esta invariancia o persistencia organizacional es
el resultado crítico de la 'autopoiesis', mientras que la
(re)producción de los componentes es el medio por el cual esto se
lleva a término de forma continuada. De ahí la definición resumida
de autopoiesis que Maturana (1975) ha empleado a veces: "Los
sistemas autopoiéticos operan como sistemas homeostáticos que
tienen su propia organización como la variable crítica fundamental
que ellos activamente mantienen constante”.
Los sistemas auto-poiéticos son además
sistemas autónomos, dado que no son dependientes de procesos de
producción externos a su organización (o hiperciclo de flujos).
Un ejemplo de esta clase de sistemas
son los organismos procariotas. Una célula viva es un caso especial
de sistema auto-poiético en el que sus componentes son moléculas.
La figura siguiente esquematiza los principales flujos moleculares
entre enzimas (proteínas catalizadoras) componentes del organismo.
La red completa es un hiperciclo que representa al metabolismo
celular.
![]() |
| Esquema de los flujos principales del metabolismo celular. El círculo central es el ciclo de Krebs |
Todo ese hiperciclo cerrado de flujos
materiales exige la vecindad de los materiales reactantes y de las
enzimas catalizadoras de las reacciones. Esta vecindad es
posibilitada por la presencia de una membrana celular cerrada que
impidiera la libre difusión de los materiales por el espacio.
Las moléculas de fosfolípidos tienen
la propiedad de que, cuando son agitadas por la turbulencia en un
medio acuoso, orientan espontáneamente sus cabezas hidrofílicas
hacia las moléculas de agua y sus colas hidrofóbicas lejos del
agua. Esto les permite formar estructuras bicapa como la de la
figura. Este parece ser el origen de las membranas biológicas, una
estructura auto-organizada sobre la que la selección natural pudo
actuar, añadiendo mecanismos metabólicos reparadores, canales y
otras sofisticaciones. Aunque son estables, tales membranas pueden
sufrir accidentes y, en esos casos, una parte del metabolismo de la
célula procariota se activa y se encarga de su reparación. Dentro
de esa estructura pudo evolucionar un metabolismo celular
auto-poiético que añadió innovaciones a la propia membrana, como
la aparición de canales con puertas que pueden sea abiertas o
cerradas por moléculas específicas, lo cual permitió la
comunicación de la célula con el medio exterior y con otras
células.
Sistemas auto-referenciales y otros
Mingers (1997) y otros autores han
diferenciado otras clases de sistemas complejos, pero no
necesariamente auto-poiéticos, que establecen relaciones circulares
de algún tipo. Los más relevantes son los siguientes:
Sistemas que se auto-influyen: Sistemas
dinámicos que tienen bucles causales o causalidad circular
(retroalimentaciones positivas o negativas). Ejemplo: Tamaño y tasa
de crecimiento de una población.
Sistemas que se auto-regulan: Sistemas
que mantienen alguna variable en un nivel particular (homeostasis).
Ej.: El sistema de regulación de la temperatura corporal.
Sistemas organizacionalmente cerrados:
Sistemas en que sus componentes y procesos son dependientes unos de
otros para el funcionamiento del conjunto y de sí mismos, pero que
no necesariamente producen sus propias componentes.
Sistemas que se auto-reconocen:
Sistemas capaces de reconocer sus propias partes (y eventualmente
rechazar otras) pero que, de nuevo, pueden necesitar de otros para su
propio mantenimiento. Ej.: Sistema inmunológico.
Sistemas que se auto-replican: sistemas
que construyen réplicas de ellos mismos. Ej.: Virus, bacterias,
organismos que se reproducen.
Varela también distinguió los
sistemas auto-referenciales. Son sistemas que organizan los estados
de sus sistemas componentes de un modo operacionalmente cerrado. Pero
no necesariamente son sistemas auto-poiéticos, pues sus componentes
pueden no estar siendo producidos por el propio sistema, sino por
sistemas exteriores. Son sistemas similares a los que Mingers (1997)
llama “autorreferentes” y que serían sistemas simbólicos o
representativos que se refieren a sí mismos ya sea por alguna forma
de señalar a la propia organización como una unidad; o por contener
una imagen de sí mismos dentro de sí mismos; o porque se refieren a
ellos mismos lingüísticamente. El cerebro podría ser un sistema
auto-referencial.
Sistemas que se auto-conocen: Sistemas
que generan identidad cognitiva. Ej.: animales con sistemas nerviosos
que interaccionan simbólicamente.
Sistemas auto-conscientes: Sistemas
capaces de interaccionar con descripciones de ellos mismos (el
observador observando al observador). Ej.: Una persona diciendo
“actué egoístamente hoy”.
Sistemas jerárquicos
Un sistema que se auto-mantiene es
habitualmente un sistema jerárquico. O’Neill (1989) define sistema
jerárquico de este modo: “un sistema disipativo es jerárquico
cuando opera en múltiples escalas espacio-temporales, esto es cuando
se encuentran en el sistema diferentes tasas de procesamiento”.
Otra definición útil que da de los sistemas jerárquicos es: "los
sistemas son jerárquicos cuando son analizables en conjuntos
sucesivos de subsistemas".
La existencia de diferentes niveles y
escalas en las que opera un sistema jerárquico implica la inevitable
existencia de formas no equivalentes de describirlo. Por ejemplo,
podemos describir a un ser humano en el nivel microscópico para
estudiar el proceso de digestión de nutrientes dentro de su cuerpo.
Sin embargo, este tipo de descripción no sería compatible con la
descripción que se requeriría para describir su "cara" a
otro ser humano (Giampietro 2005).
Los seres vivos, las sociedades humanas
y los ecosistemas son generados por procesos que operan en varios
niveles jerárquicos sobre una cascada de diferentes escalas. Por lo
tanto, son ejemplos perfectos de sistemas jerárquicos disipativos
anidados que requieren una pluralidad de descripciones no
equivalentes para ser utilizadas en paralelo para analizar sus
características relevantes en relación con la sostenibilidad.
Sistemas complejos adaptativos
Los componentes de un sistema complejo
pueden ser autómatas. Un autómata es cualquier elemento que puede
interaccionar con su entorno, tiene un código interno (o programa)
para interpretar esas interacciones y modificar su estado interno
acorde con ellas, y produce una respuesta de acuerdo con el cambio de
su estado interno. Cuando el autómata tiene sensores y programas
sofisticados de respuesta se suelen denominar agente (v.g. un
programa complejo de control de procesos, un robot, un ser humano).
La respuesta de los autómatas y agentes puede ser determinista (una
única, función del estado interno presente) o estocástico (muchas
respuestas posibles para un estado interno, que pueden obedecer, o
no, a una distribución estable de probabilidad. A veces se habla de
que un agente tiene un comportamiento “en parte determinista, en
parte estocástico”. Esto significa que responde estocásticamente,
pero que podemos predecir cómo evoluciona en el tiempo la
distribución de probabilidad de sus respuestas.
Un sistema complejo adaptativo es un
sistema: (i) compuesto de autómatas (o agentes) con un
comportamiento en parte determinista y en parte estocástico; (ii) la
respuesta (o comportamiento futuro) determinado de cada agente es una
función determinista de su estado interno, el cual depende de las
interacciones pasadas; (iii) la función determinista de respuesta (o
comportamiento determinista) está controlada por un conjunto de
reglas (o leyes) de interacción; (iv) cada agente modifica sus
reglas (o leyes) de interacción en función de los resultados
obtenidos por su comportamiento pasado.
Nótese que el punto (iv) supone
implícitamente capacidades auto-referenciales en el agente, esto es,
la capacidad de que una parte del agente sea sensible al estado del
propio agente. El agente debe ser capaz, pues, de identificar su
estado interno (efecto de su comportamiento e interacciones pasadas),
asignarle un valor a este estado, y cambiar sus reglas de interacción
en función de ese valor. Por supuesto, esta reflexividad no tiene
por qué ser necesariamente consciente; la consciencia humana de uno
mismo es una forma especial de reflexividad. Los agentes pueden
interaccionar sólo localmente, con sus vecinos próximos, o
simultáneamente con todos los agentes constituyentes del colectivo.
Esta clase de modelos se han aplicado para representar interacciones
entre humanos (modelados como agentes) sometidos a distintas reglas
morales, o a distintas estrategias inversoras en un mercado, o a
distintas preferencias políticas, etc. También se ha usado para
modelar la creación de memes o pautas de opinión en redes de
contactos o redes sociales de Internet. Otro campo de aplicación
fructífero es la teoría de juegos evolutiva (que trata de
identificar estrategias evolutivamente estables) y la toma de
decisiones colectivas.
Las ciencias de la complejidad han
seguido su curso desde sus inicios en la cibernética y la teoría de
sistemas. La figura siguiente resume dicha evolución entre los años
50 y la actualidad.
La biosfera y la hipótesis Gaia
Bertalanffy (1952 pp. 124-125) fue uno
de los primeros en caracterizar los seres vivos como estructuras que
se autoproducen y automantienen canalizando por su interior un flujo
continuo de energía y materiales que lo atraviesan:
Cuando comparamos objetos inanimados
y animados encontramos un contraste sorprendente. Un cristal, por
ejemplo, está construido de componentes invariables; persiste con
ellos tal vez durante millones de años. Un organismo vivo, sin
embargo, sólo en apariencia es persistente e invariable; en realidad
es la manifestación de un flujo perpetuo. Como resultado de su
metabolismo, que es característico de todo organismo vivo, sus
componentes no son las mismas de un momento al siguiente. Las formas
vivas no están en el ser, están sucediendo; ellos son la expresión
de una corriente perpetua de materia y energía que atraviesa el
organismo y al mismo tiempo lo constituye...
Esta concepción dinámica del
organismo puede ser contada entre los principios más importantes de
la biología moderna. Conduce a los problemas fundamentales de la
vida, y nos permite explorarlos.
Desde el punto de vista de la
física, el estado característico en que encontramos el organismo
vivo se puede definir afirmando que no es un sistema cerrado con
respecto a su entorno, sino un sistema abierto que continuamente
entrega materia al mundo exterior e incorpora materia de él, pero
que se mantiene a sí mismo en este intercambio continuo en un estado
estacionario, o se aproxima a ese estado estacionario en sus
variaciones en el tiempo.
En su libro The evolution of the
biosphere (1986) M. I. Budyko usó el término “biosfera”
para designar el Sistema constituido por todas las especies vivas. Un
hecho esencial de este sistema según Budyko es que las tasas de
intercambio de materiales que se producen entre las especies son
mucho más altas que las tasas de incorporación de estos materiales
desde otros sistemas, como la litosfera, la hidrosfera o el espacio
exterior. Además, estos intercambios de materiales sólo “se
cierran” en la escala de la propia biosfera, no en escalas más
locales como los ecosistemas particulares. Siguiendo esta
perspectiva, podemos definir la biosfera como el sistema global de
reciclado de los materiales que sirven como sustrato para el
metabolismo y autopoiesis de los seres vivos. Barlow y Volk (1990)
defienden una perspectiva similar a ésta sugerida por Budyko.
Lovelock y Margulis (1974) y Lovelock y
Watson (1982) sugirieron que la biosfera controla la temperatura, la
composición atmosférica y la disponibilidad de otros materiales que
la vida utiliza como sustrato de su metabolismo, contribuyendo así a
estabilizar las condiciones ambientales necesarias para su
supervivencia. Esta es una hipótesis muy fuerte que ha suscitado un
vivo debate desde entonces.
En su formulación fuerte, la hipótesis
no parece sostenible. El sistema regulador principal que mantiene la
temperatura del planeta aceptable para la vida es geológico: la
meteorización de los silicatos del suelo por el ácido carbónico de
la lluvia (procedente del CO2 tectónico) y su retroacción
negativa: sobre la concentración atmosférica de CO2
tanto cuando ésta es alta como cuando la temperatura es alta (véase
sección siguiente). El artículo de Kirschner (2003) ilustra otras
críticas a esta formulación fuerte de la hipótesis Gaia. Tal como
lo expone el resumen de dicho artículo: “Las incertidumbres que
rodean el cambio climático global proporcionan amplia evidencia, si
alguna fuera necesaria, de la necesidad de una visión sistémica de
la Tierra. Podría decirse que el intento más visible, y
controvertido, de entender la Tierra como un sistema ha sido la
teoría Gaia de Lovelock. Gaia ha sido un generador de hipótesis
fructíferas y ha generado muchas conjeturas interesantes sobre cómo
los procesos biológicos podrían contribuir a la regulación a
escala planetaria de la química atmosférica y el clima. En muchos
casos importantes, sin embargo, estas conjeturas son refutadas por
los datos disponibles. Por ejemplo, la teoría de Gaia predice que la
composición de la atmósfera debería estar estrechamente regulada
por los procesos biológicos, pero las tasas de absorción de carbono
en la biosfera se han acelerado en solo un 2% en respuesta al aumento
del 35% en el CO2 atmosférico desde los tiempos preindustriales. La
teoría de Gaia predeciría que el CO2 atmosférico debería ser más
efectivamente regulado por la captación del ecosistema terrestre
(que está mediada biológicamente) que por la captación oceánica
(que es principalmente abiótica), pero ambos procesos son igualmente
insensibles a los niveles de CO2 en la atmósfera. La teoría de Gaia
predice que las retroalimentaciones biológicas deberían hacer al
sistema Tierra menos sensible a la perturbación, pero los mejores
datos disponibles sugieren que el efecto neto de las
retroalimentaciones biológicamente mediadas será amplificar, no
reducir, la sensibilidad del sistema terrestre al cambio climático
antropogénico. La teoría de Gaia predice que los subproductos
biológicos en la atmósfera deberían actuar como reguladores del
clima planetario, pero el núcleo de hielo de Vostok indica que el
CO2, el CH4 y el sulfuro de dimetilo, todos subproductos biológicos,
funcionan calentando la Tierra cuando hace calor; y enfriándola
cuando hace frío. La teoría de Gaia predice que las
retroalimentaciones biológicas deberían regular el clima de la
Tierra a largo plazo, pero los picos en la paleo-temperatura se
corresponden con los picos en el paleo-CO2 en registros que se
remontan al Pérmico; por lo tanto, si el CO2 está regulado
biológicamente como parte de un termostato global, ese termostato ha
estado conectado al revés durante al menos los últimos 300 millones
de años. La teoría de Gaia predice que los organismos alteran su
medio ambiente para su propio beneficio, pero en la mayor parte de la
superficie del océano (que comprende más de la mitad del globo), el
agotamiento de nutrientes por el plancton casi ha creado un desierto
biológico, y se mantiene bajo control solo por la hambruna de
nutrientes del plancton en sí. Por último, cuando los organismos
mejoran su entorno por sí mismos, crean una retroalimentación
positiva; por lo tanto, los dos principios centrales de la teoría de
Gaia: primero, que los organismos estabilizan su entorno, y segundo,
que los organismos alteran su entorno de manera que los beneficia,
son mutuamente inconsistentes entre sí. Estos ejemplos sugieren que
el desarrollo posterior de la teoría de Gaia requerirá una
comparación más ajustada de la teoría y los datos.”
Barlow y Volk utilizan el término Gaia
y no el de biosfera, no en el sentido fuerte que le da Lovelock, sino
como forma de subrayar que esta biosfera es una entidad global que es
probablemente más autónoma, más autorregulada y más persistente
que sus ecosistemas constituyentes o los agregados de ecosistemas.
Podemos llamar a esto el planteamiento débil de la hipótesis Gaia.
Estos autores sugieren que la
naturaleza casi cerrada del sistema tierra para los flujos de
materiales impuso una presión de selección a todas las especies
desde el principio. Esta presión tendió a seleccionar las
combinaciones de especies que tenían mayores capacidades de reciclar
(conjuntamente) materiales esenciales.
Para ello se apoyan en Margulis y
Sagan, quienes describen la secuencia de eventos en la evolución de
los procariotas como habiendo sido provocada por una escasez tras
otra. Las primeras formas de vida pueden haberse alimentado de
productos químicos libremente disponibles y de ATP generado
abióticamente. La evolución de la fermentación simple liberó a la
vida de los límites impuestos por la cantidad de ATP generado
abióticamente, porque los azúcares generados abióticamente podían
ahora consumirse para generar ATP. A la escasez de azúcar le siguió
la evolución de nuevas formas de fermentación por las cuales las
bacterias podrían derivar energía de los desechos metabólicos
(ácidos y alcoholes) de otros fermentadores. Otras bacterias
desarrollaron estrategias metabólicas por las cuales el ATP era
construido desde sulfatos. Luego se produjo la evolución de
diferentes estrategias fotosintéticas que usaban la energía del sol
para construir carbohidratos a partir del último producto de
desecho, el dióxido de carbono, y alguna fuente de hidrógeno. La
disponibilidad de gas hidrógeno y de sulfuro de hidrógeno de origen
volcánico (y de los residuos metabólicos de bacterias del azufre)
puso un límite a la cantidad de actividad fotosintética que podía
inicialmente ser soportada. Pero cuando una bacteria mutante fue
capaz de extraer hidrógeno del agua, tuvo lugar un salto
cuantitativo para la biomasa. Como lo expresaron Margulis y Sagan, la
inexorable pérdida de hidrógeno que sufre un planeta interior de
baja gravedad “condujo a una de las mayores innovaciones evolutivas
de todos los tiempos: el uso del agua en la fotosíntesis. Pero
también condujo a una tremenda crisis de contaminación, la
acumulación de gas oxígeno, que era originalmente tóxico para la
gran mayoría de los organismos".
Entonces, aprovechando la nueva
oportunidad - oxígeno libremente disponible – los organismos
procariotas evolucionaron incorporando otra serie de estrategias
metabólicas: respiración con oxígeno del hidrógeno fermentable
para formar agua, de metano para formar dióxido de carbono, del
sulfuro para formar sulfito, y del amoniaco para formar nitrato.
Barlow y Volk citan también la
evolución de las técnicas de captura de nitrógeno como otro
ejemplo del papel que tuvo el cierre planetario a los materiales en
la evolución de la vida. Los procesos abióticos originales fueron
la oxidación del nitrógeno atmosférico por los rayos, que
produjeron NO, NO2 y NO3, y la fotolisis del
amoniaco que producía nitrógeno atmosférico. A estos procesos
originales, la vida añadió sucesivamente el consumo de amoníaco,
la amonificación o producción de NH3, la asimilación
de nitratos, la nitrificación (o producción de NO2 y NO3
a partir de NH3), y la fijación de nitrógeno (o
producción de NH3 a partir de N2 atmosférico).
La escasez de nitrógeno fácilmente disponible y la demanda
biológica de fuentes adicionales parecen haber sido las fuerzas
motrices en tales innovaciones evolutivas.
Diversidad biológica y resiliencia
En ecología, la resiliencia se define
como la capacidad de un ecosistema de mantener las mismas relaciones
entre sus poblaciones después de sufrir perturbaciones externas;
esto es, la magnitud de la perturbación que un ecosistema puede
soportar antes de cambiar su estructura (Holling, 1973). Sin embargo,
el concepto ha tomado un significado algo más amplio en estudios de
sistemas socio-ecológicos. Por ejemplo, como subraya
Castillo-Villanueva y Velázquez-Torres (2014), algunos autores
plantean la resiliencia como la capacidad de un sistema de mantener
sus funciones y estructuras básicas en momentos de choques y
perturbaciones (Birkmann, 2006: 15-16). Otros señalan que “la
resiliencia implica que el sistema, ya sea social, ecológico o
socio-ecológico, puede movilizar la suficiente auto-organización
para mantener las estructuras y los procesos esenciales mediante
adaptación o estrategias de supervivencia. Otros definen la
resiliencia como la capacidad de un sistema, comunidad o sociedad
para anticiparse o adaptarse a los efectos de un evento peligroso,
absorberlos o recuperarse de ellos, en forma oportuna y eficiente,
garantizando la preservación, la restauración o la mejora de sus
estructuras y funciones básicas y esenciales”. Esto es, se asume
implícitamente que el sistema puede sufrir restructuraciones en sus
componentes (e.g. especies) y en algunos de sus atractores
emergentes, pero manteniendo las funciones principales (atractores
emergentes principales).
Si definimos pues, qué
retroalimentaciones y ciclos del hiperciclo de un sistema son los
esenciales para garantizar sus funciones emergentes principales, todo
sistema, ante una variable externa perturbadora, tiene un rango de
resiliencia, un valor (con su incertidumbre asociada) para el cual la
estructura esencial del sistema sufre un cambio irreversible, y un
rango de vulnerabilidad, o rango de valores de la variable
perturbadora para el cual el sistema no puede mantener su estructura
anterior.
En ecología, hay bastante consenso en
que la biosfera como un todo ha demostrado una enorme resiliencia
ante cambios climáticos muy intensos (veremos algunos en la próxima
sección); y que esta resiliencia está asociada a la gran diversidad
de los ecosistemas terrestres. La diversidad biológica a su vez está
relacionada con la abundancia de genes diferentes, de especies, y de
hábitats.
Stuart Kauffman ha estudiado cómo ha
podido surgir y evolucionar esa gran biodiversidad utilizando modelos
de sistemas complejos de agentes adaptativos. Consideremos el
conjunto de todos los genes humanos, unos 80.000, cada uno de los
cuales puede estar activo o inactivo, según sean activados o
desactivados por la combinación de señales (traídas por proteínas)
procedentes de otros genes con los que cada gen está conectado a
distancia. El número de estados posible para una célula es de
280000, unos 1024000 estados. Si se tardara un
segundo en activar o desactivar un gen, una célula tardaría 1024000
s en explorar todos sus posibles estados, esto es, unos 426 billones
(1012) de años, necesitaría un tiempo muy superior al
que lleva existiendo el universo (13.800 millones). Las células, sin
embargo, no parecen explorar la totalidad de sus estados de
activación genética, sino más bien explorar ciclos concretos
cerrados de activaciones que, tras varias horas, o días de tiempo,
vuelven a un estado inicial.
Supongamos que una célula tiene solo
tres genes, A, B y C, cada uno de los cuales puede estar activo (1) o
inactivo (0). El conjunto de los 8 estados posibles sería:
{(000),(001),(010),(011),(100),(101),(110),(111)}. En un sistema
dinámico determinista, dado un estado del sistema en el tiempo t, el
sistema cambia a otro estado sucesor que es único, y función del
estado precedente; si el sistema no es determinista, cambia a uno de
los N estados sucesores posibles de acuerdo con cierta distribución
de probabilidad.
Supongamos que nuestro sistema de genes
celulares es determinista. La función de cambio de estado podría
ser la definida por la tabla siguiente:
T T+1
(ABC) (ABC)
(000) (110)
(001) (010)
(010) (010)
(011) (100)
(100) (011)
(101) (110)
(110) (111)
(111) (110)
Con tales reglas de transición entre
estados, el sistema genera tres bucles finales, ciclos de estados, o
“atractores” de tipo ciclo-límite, tal como se muestra en el
esquema siguiente:
(101)
(000)(110)
(111)
(001)(010)
(100)
(011)
El segundo ciclo se produce simplemente
entre el estado (010) y él mismo, o sea, más que un ciclo límite
se puede llamar un atractor estable. Estos ciclos finales pueden
llamarse “atractores”, pues atraen hacia ellos el flujo de otros
estados “transitorios”, como los estados ((101), (000), o (001).
El conjunto de los estados que fluyen hacia un atractor más los
estados que componen el propio atractor se llama “cuenca de
atracción” del atractor. Las cuencas de atracción dividen el
espacio de estados en conjuntos disjuntos.
Cuando el sistema tiene mucho más que
tres genes y reglas de transición diferentes a esta, aparecen ciclos
límite más largos, que relacionan cíclicamente a muchos genes a lo
largo del tiempo. Kauffman y otros investigadores encontraron
sistemáticamente tres formas de funcionamiento en estos sistemas de
“genes” conectados: un régimen ordenado, un régimen caótico y
un régimen fronterizo, o “frontera del caos”. En el régimen
ordenado, la mayoría de los genes permanecen activados o
desactivados la mayor parte del tiempo (generalmente dentro de un
ciclo límite largo) y cambian su estado sólo de vez en cuando, y
hay unos pocos grupos de genes que cambian de estado continuamente.
En el régimen caótico, la situación se invierte: la mayoría de
genes cambian de estado continuamente, mientras grupos aislados de
genes permanecen estables o lentamente cambiantes. La frontera del
caos es una situación intermedia entre los dos regímenes citados, y
de transición entre los mismos.
En el régimen ordenado, las longitudes
de los atractores crece de forma polinómica con el número de genes.
En la frontera del caos, el número de estados de un ciclo es
proporcional a la raíz cuadrada del número de genes. En el régimen
caótico, la longitud de los ciclos crece exponencialmente con el
número de genes.
Si, por ejemplo, la regla de transición
cambia al azar en cada interacción, el resultado es un régimen
caótico en el que la longitud típica de un ciclo de estados es de
212000 transiciones.
Dado que el ser humano tiene unos
80.000 genes, y la raíz de ese número es 283, si el genoma humano
funcionara en un régimen ordenado pero cercano al caótico (o sea,
en la vecindad o frontera del caos), debería tener ciclos de esa
longitud. El número de clases de células humanas es d 256, por lo
que Kauffman piensa que: (i) el sistema genético humano (con su
citoplasma asociado) funciona en el régimen ordenado cercano al
caos, (ii) los ciclos límite de activaciones del genoma humano
corresponden a la construcción de todas las clases de células
posibles para ese genoma; (iii) Además, el periodo de duración de
un ciclo límite completo correspondería a los tiempos
característicos de los ciclos biológicos: como lleva entre uno y
diez minutos el activar o desactivar un gen eucariótico, el periodo
de sus ciclos genéticos sería de entre 4.75 y 48 horas, un tiempo
claramente en el margen de lo biológico.
Además, en el régimen ordenado pero
fronterizo con el caos, el mal funcionamiento repentino de un gen se
propaga sólo perturbando a un número de genes que es igual como
máximo a dos veces la raíz cuadrada del número total de genes. En
el régimen caótico, la avalancha afecta a casi la totalidad de los
genes (el “efecto mariposa”, o sensibilidad exponencial a
pequeñas diferencias iniciales, es la norma en los atractores
caóticos). En la mosca Drossofila, que tiene unos 16.000 genes, la
peor avalancha debería afectar a unos 254 genes; según Kauffman, la
más grande observada hasta ahora afecta a unos 155 genes, luego el
modelo resulta hasta el momento verosímil.
El mecanismo por el cual la evolución
habría seleccionado a los organismos para que permanezcan en este
régimen sería precisamente el que la diversidad genética hace más
adaptable a una especie (al igual que hace más adaptable a un
ecosistema). El régimen fronterizo con el caos es el que más
eficazmente puede explorar las posibilidades genéticas posibles
cercanas a las que están funcionando en un metabolismo celular dado;
pero, lo hace sin que el metabolismo celular se vuelva super-crítico
(caótico) y la célula empiece a tener un comportamiento
molecularmente impredecible que sería incompatible con sus
hiper-ciclos de auto-poiesis. Si alguna célula, alguna vez, ha
traspasado esa frontera, con toda probabilidad se ha extinguido. Así
que, según Kauffman, las especies y los ecosistemas tenderían a ser
tan diversos como lo permite la dinámica de las relaciones entre
agentes adaptativos en la frontera del caos.
Uno de los parámetros que la selección
natural ha podido ir ajustando es el número K de entradas (señales
de otros K genes) a las que cada gen es sensible. Kauffman, Derrida y
Pomeau demostraron que si K=2 o inferior, las redes funcionan en el
régimen ordenado, independientemente del contenido de las reglas de
transición. Éstas pueden ser aleatorias, y aún así el
funcionamiento es ordenado. Como dice Kauffman, “si tomamos 10.000
genes al azar y los combinamos también al azar con la única
limitación de que tengan sólo K=2 entradas, aunque la función de
transición asignada a cada gen sea aleatoria (de las 16 posibles),
el sistema se las arregla para orbitar alrededor de sólo unos 100
estados de los 210000 posibles!”. Esta forma de
autoorganizarse de los sistemas complejos de agentes, combinando
cambios azarosos con atractores, sugiere que una parte importante del
orden que observamos en los seres vivos procede de procesos
autoorganizativos; y sobre ellos, actúa la selección natural
perfilando los últimos detalles, por así decirlo.
Para valores de K mayores que 2, las
redes funcionan en el régimen caótico, salvo si las funciones o
reglas de transición poseen alguno de dos tipos de sesgo. El primer
sesgo es que los genes tiendan a responder preferentemente con una
clase de respuesta (i.e. activarse; o desactivarse)
independientemente de la combinación de señales que reciba. Si la
preferencia por una respuesta es del 80% de media, por ejemplo, los
genes pueden tener 4 entradas y la red permanece en el régimen
estable; si la preferencia es del 90%, pueden llegar a tener hasta 11
entradas, etc.
La segunda clase de sesgo (“reglas
canalizadas”) es la de que la mayoría de los genes tienen alta
sensibilidad (responden siempre) hacia las señales que reciben de
algunos de los N genes, y baja sensibilidad (responden con poca
frecuencia) hacia las señales que reciben de los demás genes.
Kauffman encontró que los seres vivos utilizan esta segunda clase de
sesgo sistemáticamente, para poder tener 4, 5 y 6 entradas por gen
en algunos casos, y no utilizan la primera. Esto es, cada gen tiene
“predilección” por lo que le señalan algunos genes concretos
con los que está conectado, y reacciona más débilmente a los
demás. Es plausible que la selección natural haya partido de redes
autoorganizadas de genes con 2 conexiones por gen de media, y sobre
ellas haya explorado el “entorno posible” de ese régimen
añadiendo a la vez conexiones genéticas nuevas y reglas canalizadas
(“preferencias” limitadas entre genes), manteniéndose así en el
régimen fronterizo con el caos.
La regulación del sistema climático
La presencia de átomos radiactivos
naturales en nuestro planeta, inusual en la mayor parte del gas
interestelar, hace pensar que el sistema solar (el sol y sus
planetas) se formó dentro de la onda de choque que provocó la
explosión de una antigua supernova anterior al sol.
La ciencia geológica actual piensa que
la Tierra tiene un núcleo interno sólido donde se han acumulado por
gravedad los materiales más densos, con alto contenido en hierro,
níquel y átomos radiactivos. La desintegración de esos átomos
mantiene muy caliente al núcleo y funde a los materiales, más
ligeros, que lo rodean, que forman un núcleo externo de hierro y
níquel líquidos (entre los 2.885 y los 5.155 km de profundidad)
donde se producen corrientes de convección. Estas corrientes de
metales conductores se combinan con el movimiento de rotación de la
Tierra para crear una dinamo que mantiene el campo magnético
terrestre
Desde los años 30 del siglo XX se ha
pensado que existirían posibles corrientes de convección entre ese
núcleo externo hasta la corteza terrestre, sólida. Sin embargo,
encima de ese núcleo externo y hasta la base de la corteza terrestre
la capa existente no parece ser líquida, sino plástica, según la
tomografía sísmica, y no son posibles corrientes de convección en
un material plástico.
¿Qué causa entonces el movimiento de
las placas tectónicas de la corteza terrestre? En los últimos años,
ha aparecido una teoría que afirma que la parte de la placa que ha
subducido sigue bajando hasta el manto profundo, tirando con su peso
del resto de la placa (emergida). En contacto con el núcleo
exterior, esta placa sumergida se funde y crea penachos de material
fundido que ascienden en otro lugar geográfico, hasta encontrarse
con la litosfera, que se calienta en su base, apareciendo allí
“puntos calientes”. Estos puntos pueden generar volcanes. Las
dorsales centrooceánicas, en esta teoría, se formarían al
fracturarse la litosfera por el tirón de la placa sumergida, no
serían los impulsores del movimiento. La teoría es verosímil salvo
en que la gravedad, en un sistema estratificado, nunca puede causar
un movimiento vertical persistente a largo plazo; la elevación de
magma caliente hacia las dorsales centrooceánicas, o bien hacia los
puntos calientes, o hacia ambos, deberían seguir siendo, más
probablemente, el motor energético del movimiento tectónico.
Sea como fuere, las zonas volcánicas
cercanas a las subducciones y en las dorsales centrooceánicas son
fuentes activas de CO2, que van directamente e
indirectamente a la atmósfera, respectivamente. En Venus, este gas
se ha ido acumulando en la atmósfera hasta hacer de este planeta un
auténtico infierno para cualquier forma de vida. Esto se debe al
efecto invernadero que provoca el CO2.
![]() |
| Foto de Venus |
En efecto, en Venus
la Constant solar (potencia luminosa que entra por m2
en la alta atmosfera) es de 2637 Wm-2
, y
su albedo (fracción que vuelve reflejada hacia el espacio) es de
0.77, debido a su cobertura de nubes de ácido sulfúrico. Esto hace
que lleguen realmente 606,5 Wm-2
al suelo. Su densa atmosfera tiene un 96% de CO2
y crea una presión de 89 atm en la superfície. La temperatura en su
alta atmosfera es de Te=
227 K (-46ºC), y en superficie Ts=
737 K (464ºC); la diferencia de temperatures es provocada por el
efecto invernadero, que se puede ver que es enorme.
Marte, en cambio,
tiene una atmosfera muy tenue, de solo 0.007 atm, compuesta de CO2
al 95%.
![]() |
| Foto de Marte |
Su masa
relativamente pequeña es incapaz de retener la mayoría del gas
emitido por los volcanes, que escapa al espacio. Su constante solar
es de 592 Wm-2 con
un albedo de 0.14, por lo que llega al suelo 509,12 Wm-2.
Las temperatures sobre y bajo la atmosfera son: Te=
218 K, (-55ºC) y Ts=
220 K (-53ºC), por lo que podemos comprobar que tiene un efecto
invernadero débil. Una vida como la terrestre probablemente no
habría sido capaz de sobrevivir y evolucionar con una temperatura
superficial tan baja y tan poca agua.
La Tierra, en
cambio, tiene una constante solar de 1367 Wm-2
y un albedo de 0.30, por lo que llega a la superfície 956,9 Wm-2.
Con abundancia de agua y un 0.03% de CO2,
su atmosfera tiene un efecto invernadero moderadamente intenso: Te=
255 K (-18ºC), Ts=
288 K (15ºC).
El efecto invernadero es un
sobrecalentamiento de la superficie terrestre producido por la
presencia de gases que interceptan la radiación infrarroja emitida
por la superficie de nuestro planeta en su camino hacia el espacio, y
la reemite en todas direcciones, con lo cual una parte de esa
radiación infrarroja vuelve a la superficie. Los gases absorben luz
sólo a las frecuencias específicas que necesitan para pasar de un
estado de vibración (o rotación) menos energético a otro estado
más energético.
El vapor de agua es el principal gas
invernadero de nuestra atmósfera, pues la rotación y vibración de
su molécula intercepta la mayor parte de la radiación infrarroja
emitida por la superficie (Figura). Pero el CO2 produce efecto
invernadero también porque varios modos de vibración de su molécula
necesitan absorber ondas infrarrojas de frecuencias de 1.8, 4.5 y 12
micrometros, y esas frecuencias coinciden con ventanas que la
rotación y vibración de la molécula de agua deja abiertas, esto
es, el vapor de agua no intercepta esas frecuencias infrarrojas.
Como la atmósfera está bastante
saturada de vapor de agua, sus aumentos de concentración aumentan el
calentamiento de la superficie, pero no tanto como lo que
correspondería al aumento de concentración, debido a que las
ventanas de absorción que le corresponden están ya casi saturadas
(casi toda la radiación procedente de la superficie ha sido
interceptada ya, y el que haya aún más vapor cambia poco el
panorama). Este no es el caso del CO2, que al estar en
concentraciones relativamente bajas en la atmósfera, una duplicación
de su concentración induce casi una duplicación de su efecto
invernadero.
En cualquier caso, cuando el CO2
aumenta su concentración, provoca una subida de la temperatura media
de la superficie. Esa subida térmica aumenta un poco más la
evaporación del agua de los océanos y suelos, y el aumento
consiguiente de vapor de agua atmosférico aumenta en una cantidad
adicional el efecto que le correspondería al CO2 en
solitario. Cuando los climatólogos habla del aumento del “efecto
invernadero” causado por un aumento de CO2 antropogénico
se están refiriendo al efecto combinado (directo e indirecto, a
través de la evaporación) de ese aumento de CO2.
La Tierra pasa por eras geológicas de
alta actividad tectónica (y por tanto, volcánica) y por periodos de
baja actividad. Las épocas de alta actividad tectónica son también
épocas de alta emisión de CO2 a la atmósfera, dorsales
oceánicas más voluminosas, en consecuencia el océano está más
alto, y hay también una deriva más rápida de los continentes.
Esas épocas suelen coincidir con
fuertes aumentos del CO2 atmosférico, como muestra la Figura
siguiente. Sin embargo, esta figura muestra también que, a lo largo
de la historia de la Tierra, el CO2 no se ha ido
acumulando como ha ocurrido en Venus, sino que siempre ha estado en
concentraciones moderadas, entre las de las épocas glaciales (33%
inferiores a la actual) y las del Ordovícico (unas 17 veces superior
a la actual).
¿Qué mecanismo planetario mantiene la
concentración de CO2 acotada en esos márgenes? La
hipótesis que formuló Lovelock con su hipótesis Gaia fue que la
propia biosfera es la que mantiene a ese gas (y a otros) dentro de
márgenes tolerables para la vida. Sin embargo, la explicación más
aceptada es que el mecanismo principal de esa regulación es la
meteorización química de los silicatos del suelo por acción del
ácido carbónico, esquematizada en la Figura siguiente.
Esencialmente, una parte del CO2
presente en la atmósfera se disuelve en las gotas de lluvia; allí,
una parte del CO2 disuelto pasa a ácido carbónico
disuelto, H2CO3, y éste, cuando las gotas de
lluvia tocan las rocas del suelo, reaccionan con los silicatos
presentes en éstas y los convierte en carbonatos y bicarbonatos. Las
raíces de la vegetación disgregan las rocas silíceas y amplifican
la formación de ácido carbónico (con ayuda de sus bacterias
asociadas), por lo que ayudan a la meteorización. La reacción
agregada sería:
CaSiO3
+ H2O + CO2
CaCO3 + SiO2
+ H2O
Roca Lluvia Vulcanismo Carbonato
Silícea
Llevados por los ríos hasta el mar,
los carbonatos fluviales van sedimentando por el camino, y los
bicarbonatos disueltos precipitan en forma de carbonatos sólidos,
por acción de los organismos marinos, que crean estructuras óseas y
conchas a partir de ellos. Así, la meteorización retira CO2de la atmósfera y lo deposita, en forma sólida estable, en los
fondos marinos. De allí, en plazos muy largos de unos millones de
años, estos carbonatos son arrastrados por el movimiento del fondo
oceánico hacia las subducciones, y tras fundirse bajo los
continentes, regresan a la atmósfera mediante el vulcanismo. El
flujo de carbonatos de origen abiótico es unas cuatro veces mayor
que el flujo biótico desde el bicarbonato disuelto hacia los fondos
marinos (Figura próxima). Esto sugeriría que la meteorización era
un mecanismo previo a la aparición de la biosfera, pero que ésta ha
acabado contribuyendo con una aportación importante (y reforzante) a
una parte de su ciclo; sin embargo, ese efecto reforzante del
termostato geológico de la biota marina es arruinado por la dinámica
de la biota terrestre, como comentamos, que actúa aumentando la
emisión de CO2 cuando el CO2 está alto en la atmósfera, y
viceversa.
![]() |
|
Ciclo geológico del carbono. Tomado
de Zhong et al. (2018).
|
Hay además una retroalimentación
negativa múltiple entre la subida de concentración de CO2
en la atmósfera y la retirada de CO2 de la atmósfera por
efecto de la meteorización. Por una parte, la reacción de
meteorización aumenta su tasa de actividad cuando la concentración
de CO2 (y con ello, la temperatura) es más alta; por
otro, en las épocas de mucho CO2 en atmósfera hay más
flujo de este gas hacia las gotas de lluvia y mayor formación de
ácido carbónico reactante; finalmente, si la temperatura global es
más alta, hay mayor tasa de evaporación y por tanto de
precipitación, con lo que aumenta la cantidad de ácido carbónico
que llega al suelo y lo ataca químicamente.
La retroacción entre temperatura y
meteorización controla la concentración atmosférica de CO2
(y con ello la temperatura media de la superficie) no sólo por
arriba sino también por abajo, tal como ilustra la figura siguiente,
por lo cual constituye un eficaz “termostato” climático en la
Tierra.
Este mecanismo de regulación parece
haber salvado el clima del planeta en varios momentos críticos, y
haberlo mantenido apto para la evolución de la vida.
Uno de esos momentos críticos fue
probablemente el de hace 4000 millones de años, cuando el sol, más
joven y frio, debió brillar con un 30% menor intensidad que
actualmente. Esto debió haber impedido la existencia de agua líquida
en superficie, en contra de las evidencias geológicas. La solución
más creíble para esta paradoja (planteada por Carl Sagan y G.
Mullen en los años 70) es que en esa época la concentración de CO2
en atmósfera debió ser mayor (por el mayor flujo de calor desde el
interior terrestre y la mayor actividad tectónica); y la
relativamente baja temperatura debió provocar una baja meteorización
de ese CO2.
Otros momentos críticos debieron
producirse en le precámbrico tardío (1000 a 560 millones de años
BP). En ese periodo hay evidencia de al menos dos (y posiblemente
más) glaciaciones anormalmente grandes. La primera (“Sturtian”;
~730 millones BP) pudo haber provocado una auténtica “Tierra bola
de hielo” pero han quedado poquísimos datos geológicos como para
poder afirmarlo con seguridad. La más reciente (~650 a ~560 millones
BP), parece haber provocado efectivamente una “Tierra bola de
hielo” con evidencias claras de hielo marino llegando al ecuador.
Entre los sedimentos geológicos
correspondientes a esta época, se encuentran en efecto sedimentos
que se depositan sólo en glaciares o icebergs; sin embargo, estos
sedimentos se observan incluso en regiones que se encontraban
entonces en el ecuador.
Otra evidencia son las rocas con bandas
de hierro. Tales rocas dejaron de formarse en 1800 Ma BP, porque el
alto oxígeno disuelto (que alcanzó probablemente el océano tras la
fotosíntesis) lo impidió. Sin embargo, en -700 Ma BP vuelven a
formarse, asociados a depósitos glaciares en todos sitios. Como si
el océano hubiera permanecido anóxico millones de años, y de
repente, se hubiera vuelto oxigenado.
![]() |
| Roca con bandas de hierro |
¿Cómo pudo enfriarse tanto el planeta
pese al termostato de la meteorización? Una explicación plausible
es que, en aquella época, los continentes pudieron estar todos entre
los dos trópicos. Los dos polos relativamente aislados de corrientes
oceánicas provocan, según los modelos climáticos globales, una
alta retroacción positiva del albedo polar sobre el enfriamiento (el
casquete de hielo que crece en los polos vuelve más reflectiva la
superficie, lo cual disminuye más la temperatura, lo cual aumenta la
extensión del casquete de hielo). Los casquetes polares debieron
crecer sobre el mar y su crecimiento no inhibía directamente la
formación de carbonatos (separando las rocas de la lluvia), porque
estos seguían formándose en los continentes sin hielo.
Una vez los casquetes alcanzaron los
30º de latitud, los modelos dicen que el enlentecimiento de la
meteorización por la bajada térmica fue incapaz de contrarrestar ya
a la retroacción positiva del albedo sobre el enfriamiento. El hielo
debió envolver la Tierra hasta el ecuador, mientras el océano se
congelaba hasta una profundidad de 1000 m.
El planeta podría no haber salido
nunca de ese estado, enormemente estable. Sin embargo, esta
glaciación aberrante terminó misteriosamente sólo un poco antes de
la “explosión cámbrica” de los seres pluricelulares. ¿Qué
mecanismo “salvó” al planeta? La explicación más plausible es
la de que los volcanes seguían emitiendo CO2. La bajísima
evaporación, impedía que hubiera nubes de lluvia, por lo que sin
gotas de lluvia, no se formaba ácido carbónico, ni había
posibilidad de meteorización. Por tanto, el CO2
permanecía en la atmósfera. Tras unos 10 millones de años, los
modelos nos dicen que el CO2 debería haber subido hasta
1000 veces su concentración atmosférica!
Ante un efecto invernadero tan intenso,
las comarcas sin hielo alrededor de las fuentes geotérmicas y de los
volcanes continentales sufrirían un calentamiento que fundiría todo
los hielos de sus alrededores, según los modelos. Esto provocaría
una bajada del albedo regional, aumentaría las temperaturas en tales
regiones, abriendo más y más los huecos sin hielo, por la
retroalimentación positiva y creciente de la bajada del albedo y el
aumento de temperatura.
Cuando una fracción importante de la
superficie se vio liberada del hielo, la acción reguladora de la
meteorización se habría reiniciado, bajado el nivel de CO2
a sus valores normales. Así pues, una vez más, el termostato de la
meteorización pudo haber “salvado” al planeta, volviéndolo
favorable a la evolución de los organismos pluricelulares.
¿Dónde pudo sobrevivir la vida
unicelular (bacteriana) del Precámbrico? Probablemente, en las
fuentes geotérmicas continentales, alrededor de las chimeneas
volcánicas oceánicas y, algunas células, en las grietas del hielo
flotante. Las especies supervivientes de esa catástrofe, pudieron
quizás ser especialmente adaptables como sugiere la explosión de
formas vivas que se produjo a continuación tras el fin de esta
glaciación extrema.
Otras situaciones que resultaron
críticas para la vida sobre el planeta, pero que la resiliencia
biosférica pudo resistir, fueron las cinco grandes extinciones
masivas: la del Ordovícico-Silúrico (439 millones a BP, 85% de
especies), la del Devónico-Carbonífero (367 millones a BP, 82% de
especies), la del Pérmico-Triásico (210 millones a BP, 96% de
especies), la del Triásico-Jurásico (210 millones a BP, 76% de
especies), y la del Cretácico-Terciario (65 millones a BP, 76% de
especies). La causa de la primera es completamente incierta (se ha
especulado con la explosión de una supernova cercana), mientras que
el resto pudieron ser causadas por emergencia de magma y erupciones
volcánicas masivas (acompañadas en algún caso por el impacto de un
gran meteorito).
En la del Pérmico-Triásico, hay
evidencias de una caída muy importante de la concentración de
oxígeno: del 35 % de comienzos del Pérmico al 15% al final del
período (Berner, 1999), quizás provocado por la anormal bajada del
nivel del mar, que expuso a la oxidación al 70% de las plataformas
continentales, ricas en sedimentos carboníferos. La reducida presión
parcial de oxígeno por encima de unos pocos centenares de metros de
altitud fue desalojando de allí lentamente a muchos cuadrúpedos,
que se habían acostumbrado a un metabolismo muy consumidor de
oxígeno. La escasez de oxígeno dio ventaja a las bacterias
metabolizadoras de azufre sobre las aerobias, lo que aumentó las
emisiones de sulfídrico y de metano por los océanos. A mitad del
periodo, el choque de China Sur con la placa del Mar de Thetis
produjo un accidente geológico anormal, que fue el ascenso masivo de
magma a través de depósitos de carbón, que liberó a la atmósfera
170 trillones de toneladas de CO2, 18 trillones de
toneladas de ácido clorhídrico y gran cantidad de metano.
Finalmente, 5-10 millones de años después, se produjo una segunda
crisis tectónica en Siberia, con la emisión de 1-4 millones de m3
de lava basáltica que cubrió una superficie casi igual a la
europea, quemando grandes extensiones de bosques. Este segundo pico
de gases invernaderos y aumento térmico favoreció entonces la
autocombustión de grandes masas de carbón que se habían generado
desde el Carbonífero. Esto aún produjo más CO2 y
disminuyó aún más la concentración de oxígeno en la atmósfera,
que llegó a ser del 16%. Las aguas de los mares se calentaron,
liberando los depósitos de metano congelado próximos a la costa,
con lo que se incrementó aún más el efecto invernadero. Esto
volvió aún más anóxico a los océanos, que vertieron tanta
cantidad de sulfuro de hidrógeno que las costas, donde se habían
refugiado muchas especies, se volvieron inhabitables. Se extinguieron
el 96% de las especies, y hasta la mayoría de los insectos.
En la del Triásico-Jurásico, el
super-continente Pangea comenzó a fracturarse a lo largo de una
línea de ruptura llamada “Central Atlantic Magmatic Province”
(CAMP). En esa enorme región geográfica de unos tres millones de
Km2 (figura) empezaron a emerger, una vez más,
gigantescas coladas de basaltos, que provocaron continuas lluvias
ácidas provocadas por las emisiones de SO2, y un probable
calentamiento brusco provocado por el aumento del CO2.
La extinción del Ordovícico-Silúrico
es incierta, pero pudo ser provocada por la explosión de una
supernova cercana. Si una de estas explosiones sucediera lo
suficientemente cerca destruiría la capa de ozono de la atmósfera.
Esto nos expondría a la radiación ultravioleta del Sol, que además
romperían el oxígeno hasta en las capas bajas de la atmósfera,
formando ozono a ras de suelo, gas que, a ese nivel, es tóxico para
la vida animal y vegetal. ¿Puede la biosfera adaptarse a cualquier
perturbación? Está claro que la biodiversidad es y fue una gran
baza, pero no garantiza la supervivencia en cualquier situación
geológica. Un ejemplo es la evolución geológica de Venus.
¿Por qué la superficie terrestre no
es un infierno, como lo es la superficie de Venus? Venus es una
especie de gemelo de la Tierra por su masa, y aun estando más cerca
del sol, la cantidad de radiación que llega a su superficie es menor
que la que llega a la Tierra (debido a su densa atmósfera). Sin
embargo, ha evolucionado geológicamente de una manera absolutamente
hostil para cualquier forma de vida que conozcamos. La explicación
más plausible está relacionada, sorprendentemente, con la diferente
velocidad de rotación de ambos planetas.
La velocidad de rotación de Venus es
de una vuelta cada 243 días terrestres. Esta rotación tan lenta
produce un efecto dinamo inapreciable en un probable núcleo exterior
líquido como el de la Tierra. Por lo que tiene un campo magnético
planetario prácticamente inapreciable. En cambio, la Tierra tiene a
su alrededor un campo magnético desarrollado, tal como muestra la
figura.
El sol emite un flujo supersónico
continuo de protones, electrones y núcleos de helio, llamado viento
solar. Estos iones tienen una energía entre 1.5 y 10 kEV, unas
30-200 veces más que la energía de ionización y rotura de la
molécula de agua, de modo que una molécula de agua tiene pocas
probabilidades de sobrevivir al choque con uno de estos iones de alta
energía. El campo magnético de la Tierra, sin embargo, curva la
trayectoria de estos iones alrededor de la Tierra, de manera que sólo
unos pocos consiguen alcanzar nuestro planeta, casi todos en las
regiones polares, donde ionizan o excitan los átomos de nitrógeno,
oxígeno y agua, y producen las auroras boreales (cuando los átomos
o iones excitados vuelven a su estado fundamental de energía
emitiendo fotones). La mayoría de los iones del viento solar, sin
embargo, continúa su camino hacia el exterior del sistema solar.
En contraste con la Tierra, ningún
escudo magnético protege la atmósfera de Venus. Los iones del
viento solar inciden directamente contra las capas altas de su
atmósfera. El vulcanismo de Venus, como el de la Tierra, debe de
haber estado vertiendo a la atmósfera (principalmente) CO2
y agua desde hace varios miles de millones de años. Como el agua es
más ligera que el CO2, flota sobre él, y tiende a
colocarse encima, así que el agua en Venus ha debido ir colocándose
en la atmósfera alta, a lo largo de millones de años, mientras el
CO2 iba llenando su parte baja. Lo que ha debido ocurrir
lo podemos imaginar, y ha sido en parte confirmado por las imágenes
y datos enviados por la sonda Venus Express de la Agencia Espacial
Europea (ESA) en 2006 (foto siguiente).
![]() |
|
Interacción entre Venus y el viento
solar (Crédito: ESA / C. Carreau)
|
La sonda Venus Express (1270 kg), en
órbita polar entre 250 y 66000 km de Venus, fue lanzada en Noviembre
de 2005 por un cohete Soyuz, alcanzó Venus tras 153 días de viaje y
tras 5 días de maniobras controladas por radio desde la Tierra (a 40
millones de km), consiguió su órbita.
Una de las primeras fotografías
enviadas mostró, en el lado nocturno de Venus, una estela turbulenta
de átomos abandonando el planeta. Pues bien, el “Analyser of Space
Plasma and Energetic Atoms” (ASPERA) de la sonda mostró en la
composición de esa estela una proporción de dos átomos de
hidrógeno saliendo por cada uno de oxígeno. ¡Venus está perdiendo
continuamente agua ionizada! Y probablemente la ha estado perdiendo
por más de 3000 millones de años, por lo que su atmósfera
ahora tiene ahora 1/105 veces menos agua que la atmósfera terrestre.
Así pues, esa foto nos hace testigos
de la tragedia de Venus. Sin agua en su atmósfera, el CO2 de los
volcanes de Venus no puede formar ácido carbónico; La retroacción
negativa de la meteorización no existe; el CO2 se acumula
continuamente, mientras que el agua es descompuesta por el viento
solar en su alta atmósfera, y va abandonando el planeta en forma de
iones de alta velocidad. Tres o cuatro mil millones de años más
tarde, la temperatura en su superficie es de cerca de 500ºC, llueve
ácido sulfúrico, y la presión es tan alta (89 atm) que las
primeras naves Venera que llegaron intactas a su superficie, filmaron
una imagen óptica lechosa, como de estar sumergidos en algo más
parecido a un líquido que al aire que conocemos.
Probablemente, las primeras células
vivas que evolucionaron en la Tierra (ya sea por síntesis química
estilo Oparin y Miller, ya sea por panespermia desde los cometas) se
beneficiaron de ciclos reguladores del clima tal como la
meteorización, y sobre ese contexto geológico construyeron sus
propias dinámicas, que en algunos casos refuerzan la regulación
climática geológica y en otros la debilita ligeramente sin
inutilizarla. La biosfera ha evolucionado, como hemos visto, en el
contexto de unas fuerzas, ciclos y eventos geológicos que, en muchos
casos, eran demasiado poderosos y tenían una causación demasiado
remota como para que la adaptación biológica pudiera afectarlos.
Pero la biosfera era lo suficientemente resiliente, debido a su
diversidad, para que un pequeño número de especies sobrevivieran a
las grandes catástrofes, y repoblaran el planeta.
Artículo escrito por Antonio García-Olivares
Referencias
Barlow C. & Volk
T. (1990). Open systems living in a closed
biosphere: a new paradox for the Gaia debate. BioSysrems,
23, 371—384.
Bertalartffy, L.V.,
1952, Problems of Life: An Evaluation of Modem Biological Thought,
(John Wiley, New York).
Birkmann, Jörn,
2006: "Measuring vulnerability to promote disaster-resilience
societes: conceptual frameworks and definitions", en Birkmann,
Jörn. (Ed.): Measuring Vulnerability to Natural Hazards: towards
disaster resilient societies, New Delhi, India: Teri Press.
Castillo-Villanueva L.,
Velázquez-Torres D. 2015. Sistemas complejos adaptativos, sistemas
socio-ecológicos y resiliencia. Quivera, vol. 17,
núm. 2, 2015
HEJL, P. M. (1984)
Towards a Theory of Social Systems: Self-Organization and
Self-Maintenance, Self-Reference and Syn-Reference, in
Self-Organization and Management of
Social Systems, H. Ulrich and G. J. B.
Probst (eds.), Springer, Berlin.
Holling C. S.
(1973). Resilience and Stability of Ecological Systems. Annual Review
of Ecology and Systematics, Vol. 4, pp. 1-23.
KAUFFMAN, S. (1995),
At Home in the Universe, The Search for
the Laws of Self-Organization and Complexity.
Oxford University Press, New York.
KAUFFMAN, S. (2003), Investigaciones,
Barcelona,Tusquets.
Kirchner J. W. 2003.
The Gaia Hypothesis: Conjectures And Refutations. Climatic
Change 58: 21–45
Lovelock, J.E. and
Margulis, L., 1974, Atmospheric homeostasis by and for the biosphere:
the Gala hypothesis. Tellus 26, 1--9.
Lovelock, J.E. and
Watson, A.J., 1982, The regulation of carbon dioxide and climate:
Gaia or geochemistry, Planet. Space Sci. 30, 795--802.
Maturana, Humberto
R. (1975). The organization of the living: A theory of the living
organization, International Journal of Man-Machine Studies, Vol. 7,
pp. 313-332.
Mingers J. 1997.
Systems Typologies in the Light of Autopoiesis: A Reconceptualization
of Boulding's Hierarchy, and a Typology of Self-Referential Systems.
SYST. RES. BEHAV. SCI. VOL. 14, 303-313.
O’Neill, R.V.:
Perspectives in Hierarchy and Scale. In: J. Roughgarden, R.M. May and
S. Levin (eds.): Perspectives in Ecological Theory. Princeton
University Press, Princeton, 1989, pp. 140–156.
Rosen R. 1993.
Drawing the boundary between subject and object: comments on the
mind-brain problem. Theoretical Medicine 14.
Varela, Francisco J.
(1979). Principles of Biological Autonomy, New York: Elsevier (North
Holland).
Zhong Y.J., Huang
K.K., Lan Y.F., Chen A.Q. 2018. Simulationof Carbon Isotope Excursion
Events at the Permian-Triassic Boundary Based on GEOCARB. Open
Geosci. 10: 441–451.

No hay comentarios:
Publicar un comentario
NO SE ADMITEN COMENTARIOS ANÓNIMOS